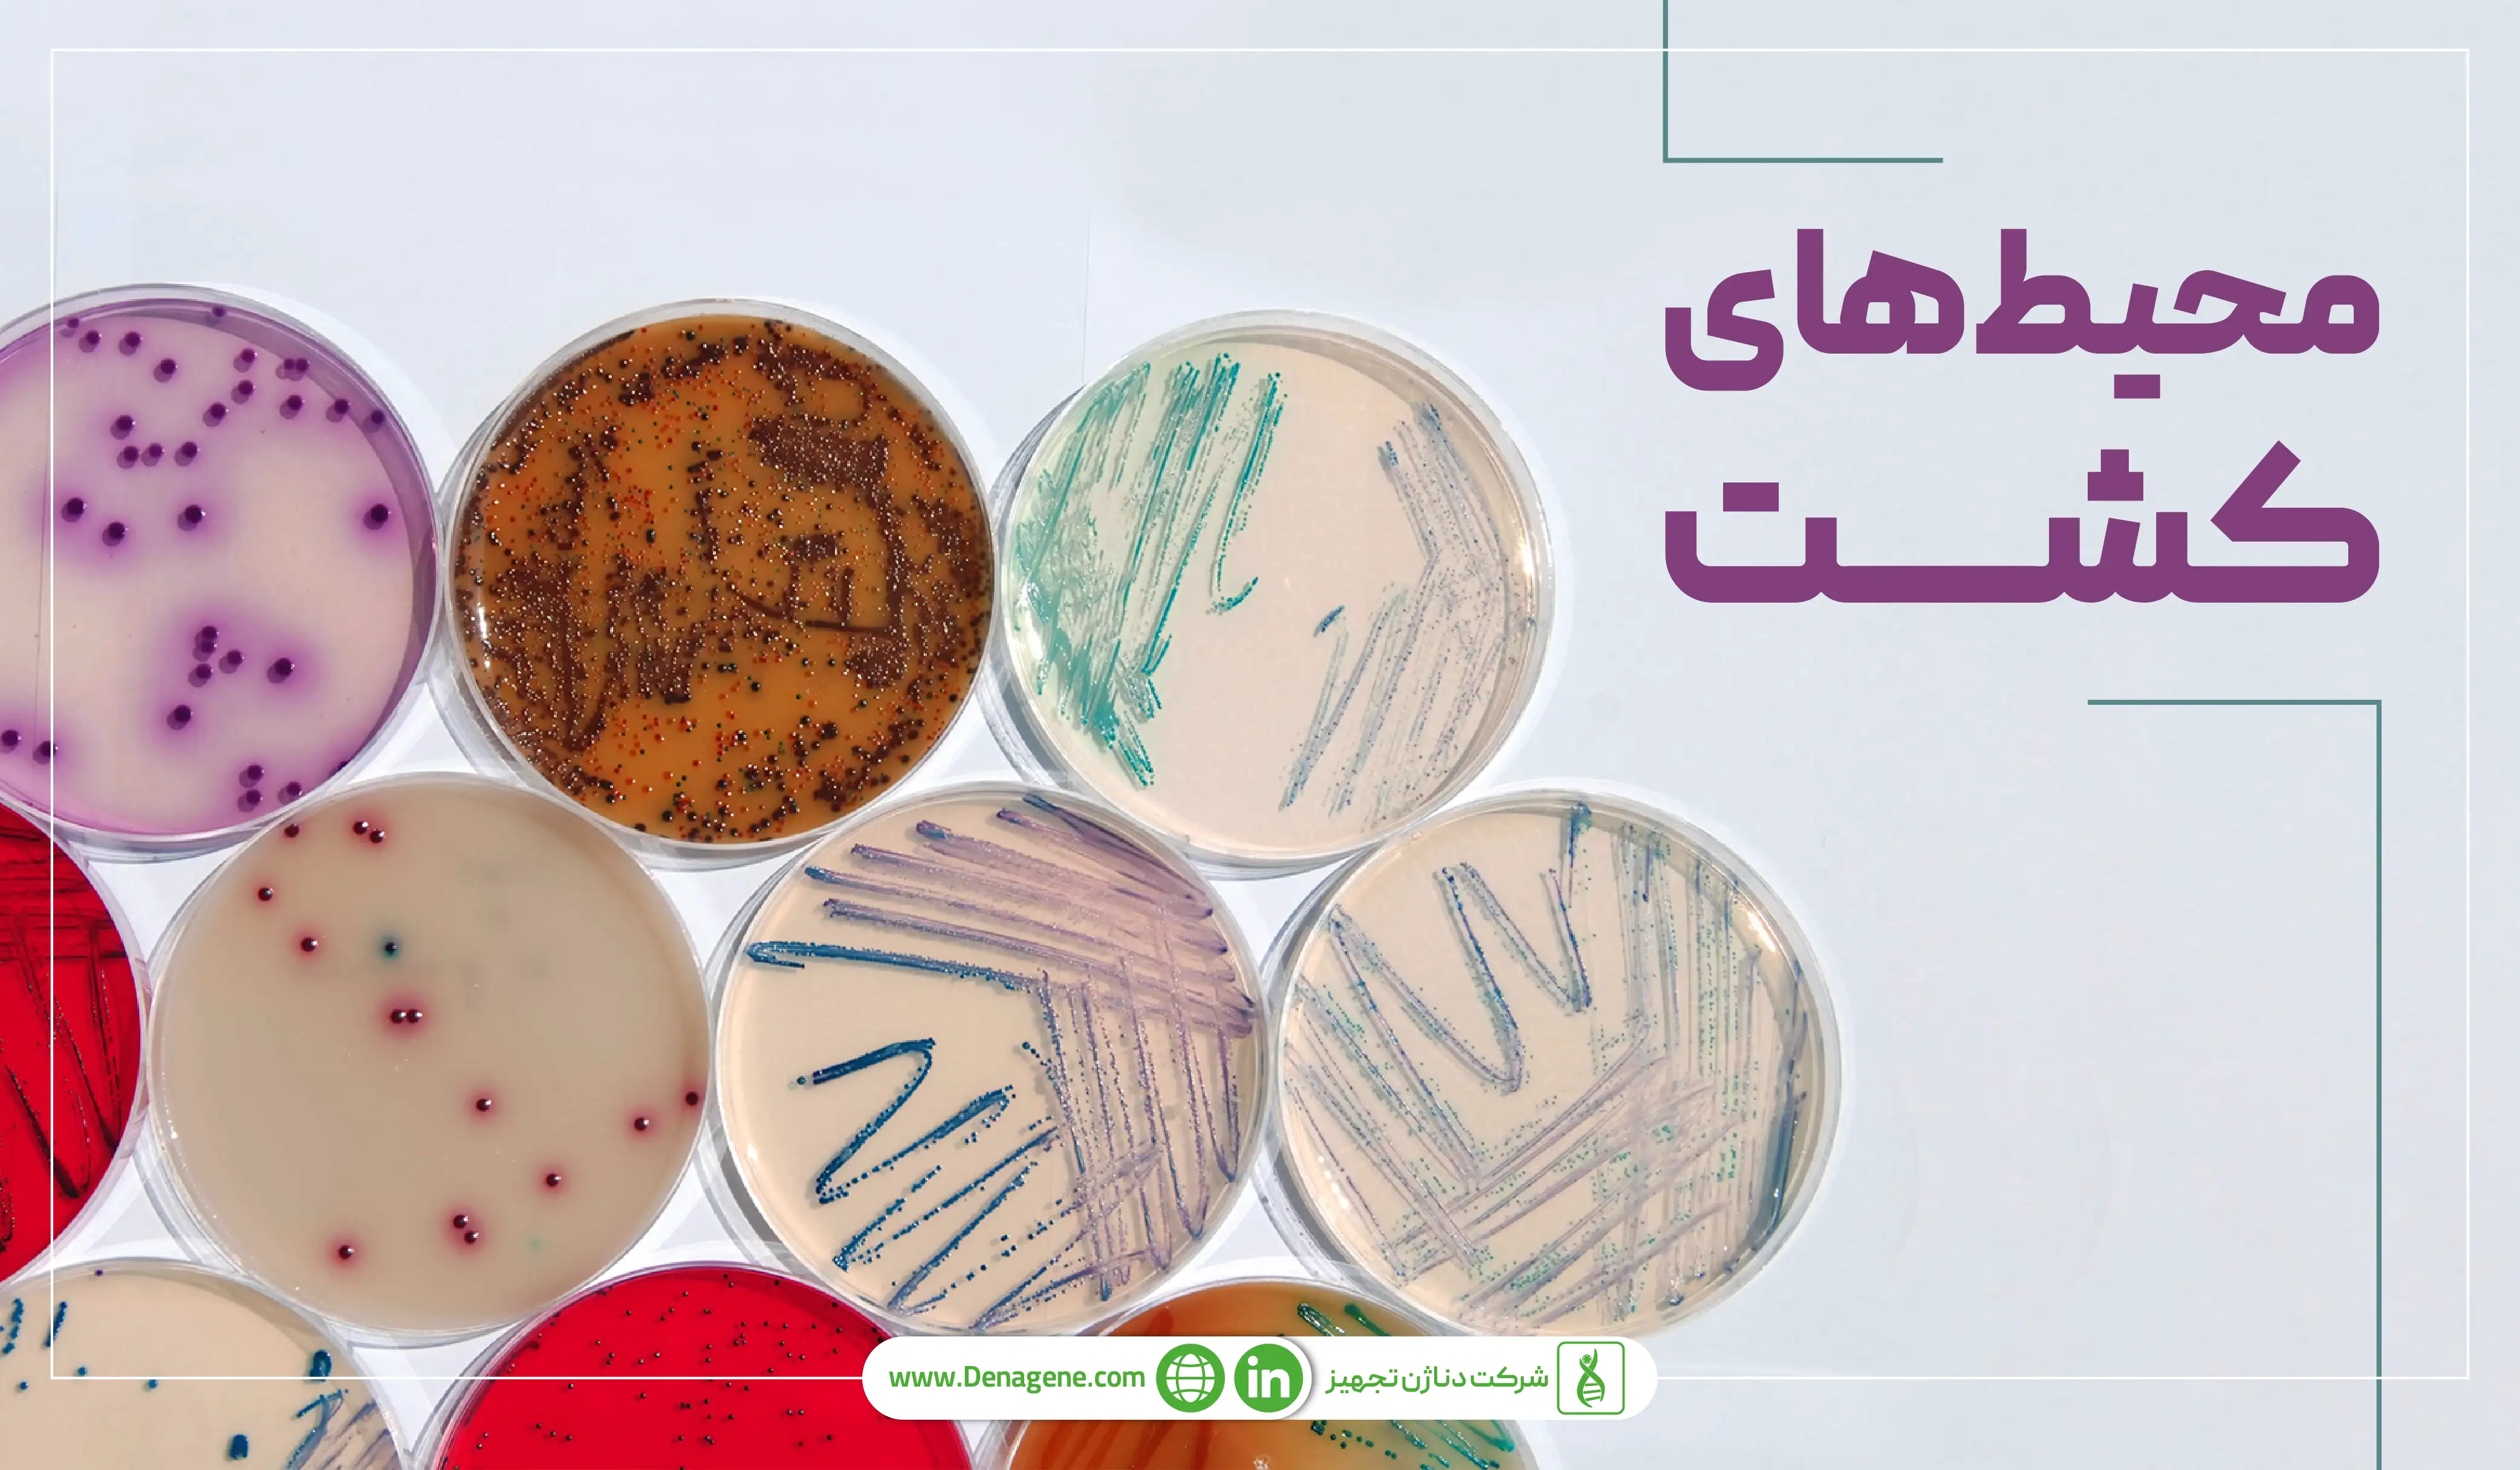
محیط‌های کشت سلولی
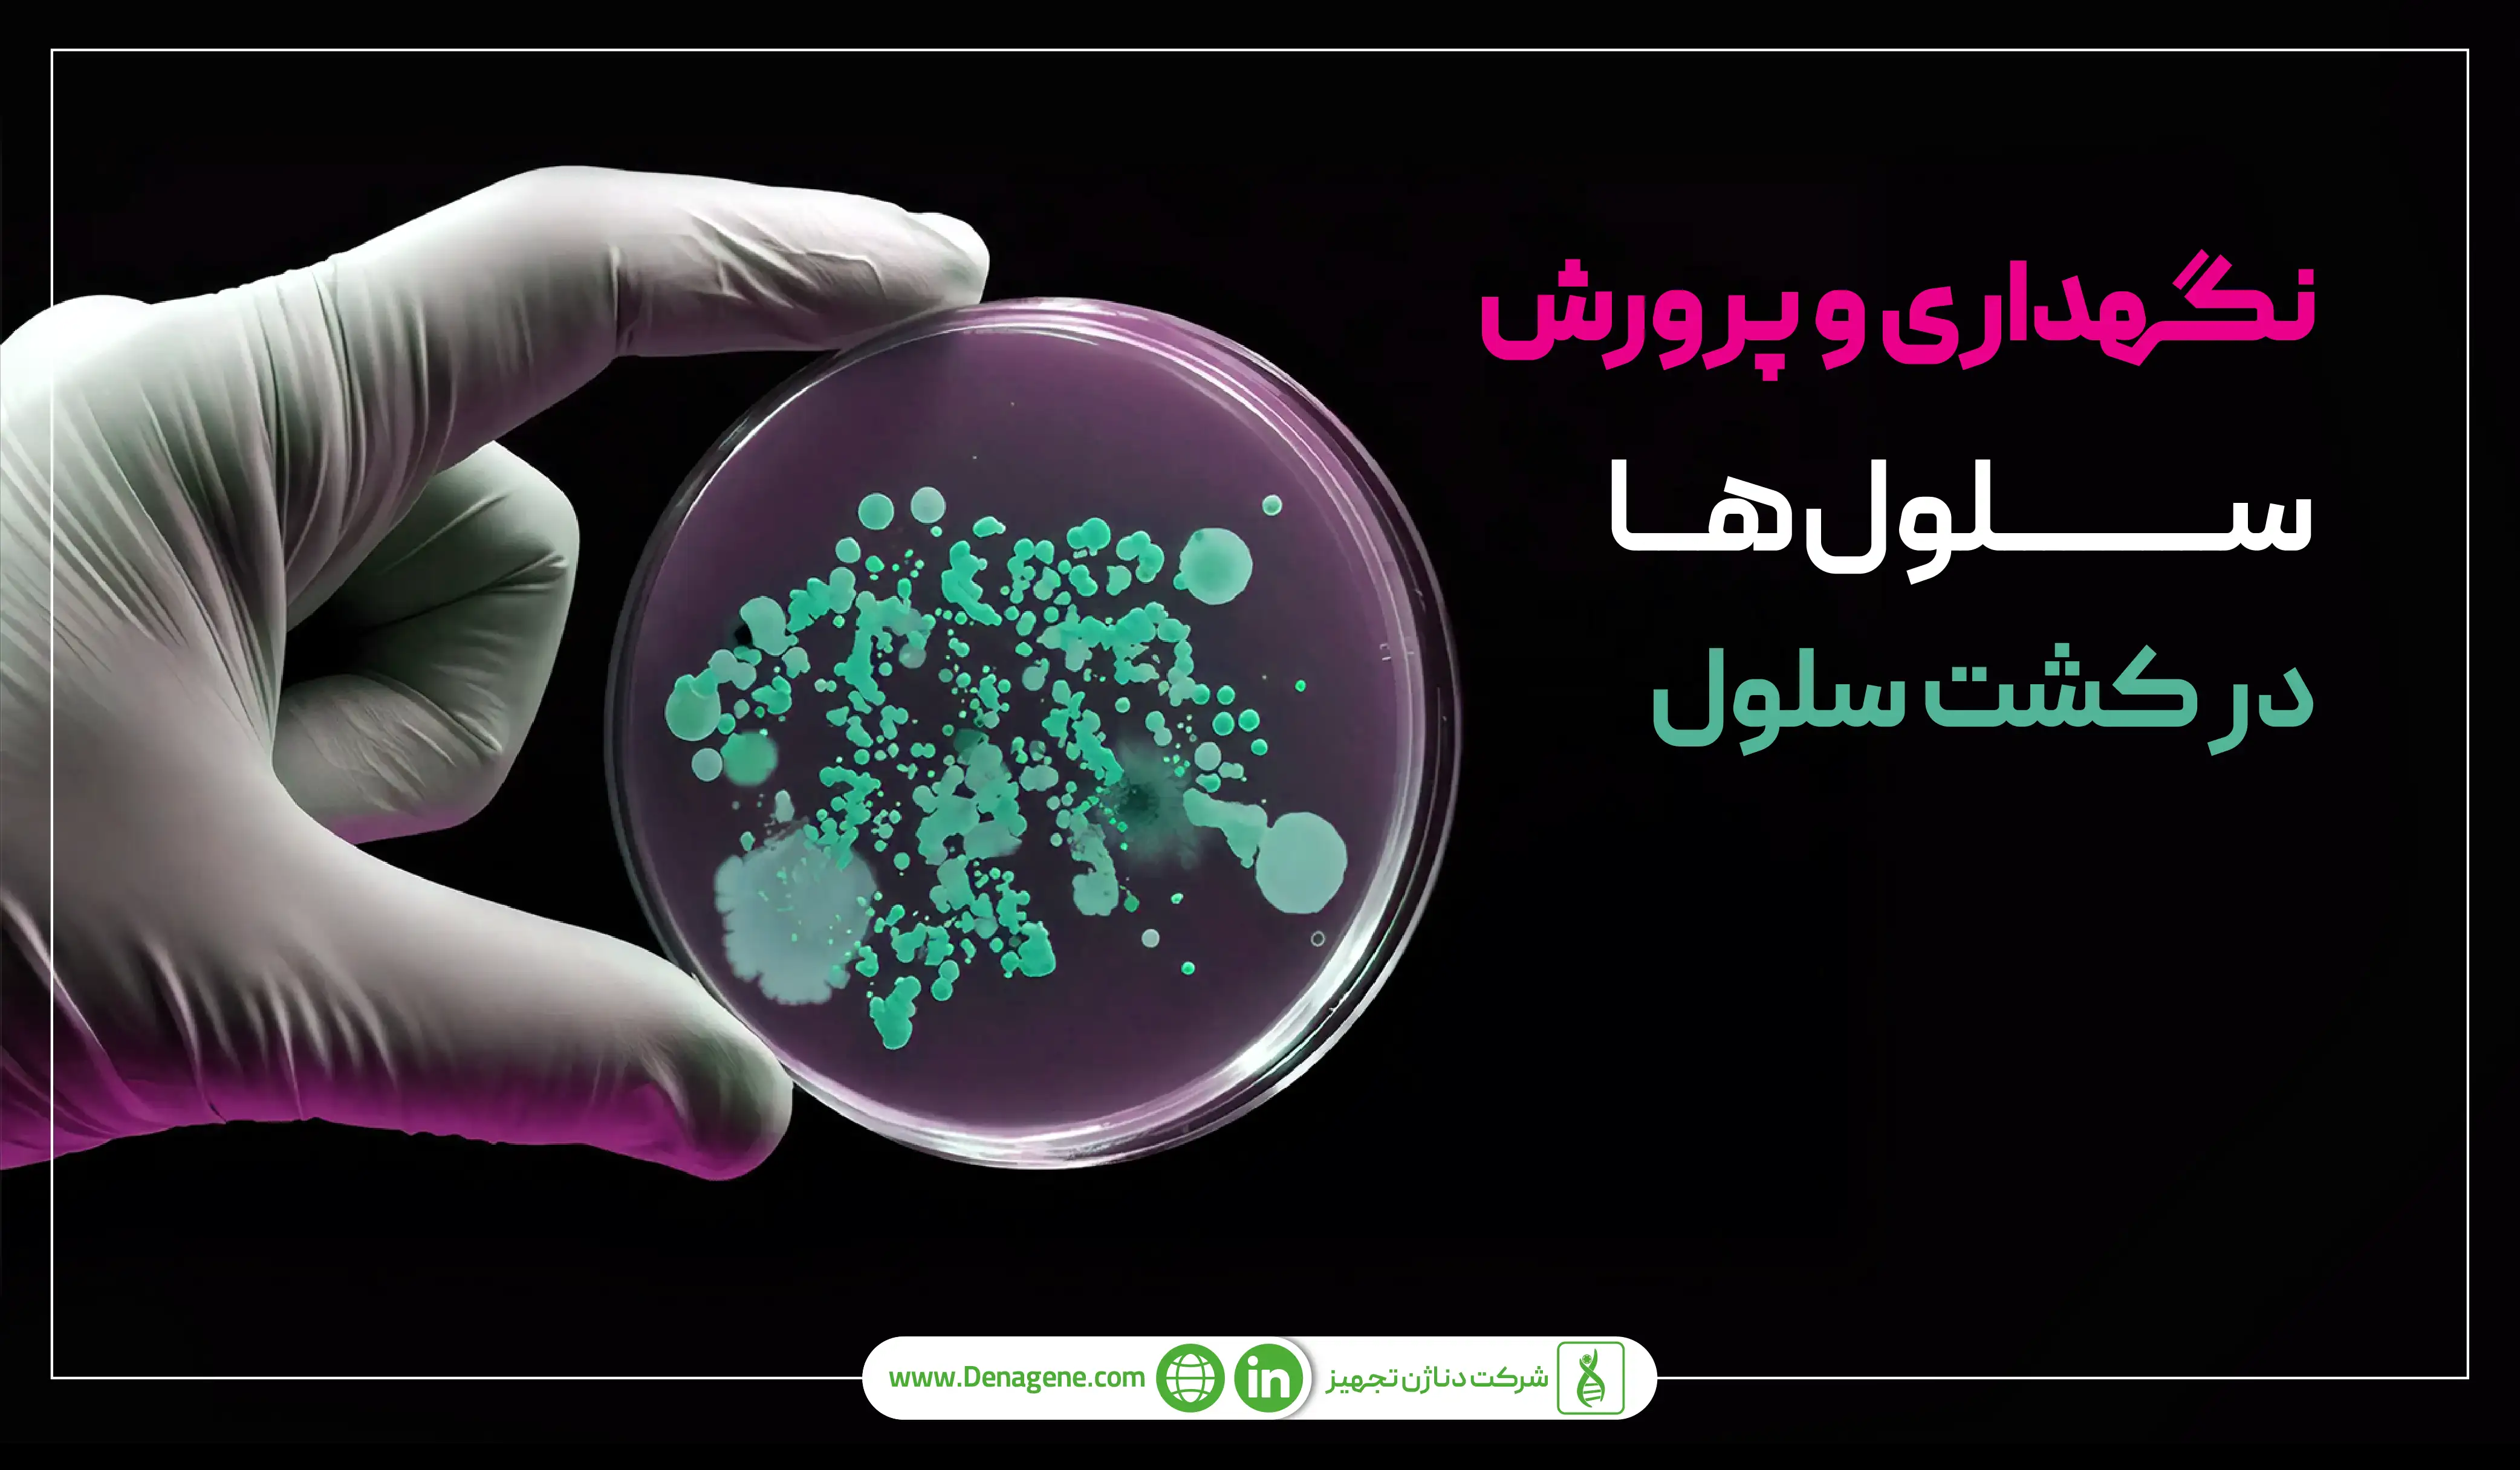
نگهداری و پرورش سلول‌ها در کشت سلول

کشت سلول (Cell Culture) در زیستشناسی مدرن اهمیت بالایی دارد و به معنای نگهداری و رشد سلولها در محیطی کنترلشده و خارج از بدن موجود زنده (in vitro) است. این تکنیک، ابزاری قدرتمند برای مطالعه فرایندهای بیولوژیکی، توسعه داروها، تولید واکسنها و انجام تحقیقات پیشرفته در زمینههای مختلف علوم زیستی و پزشکی محسوب میشود. در این مقاله به مراحل و روشهای کشت سلول در پزشکی بیشتر میپردازیم با مجموعه دناژن تجهیز همراه باشید.
کشت سلول به معنای پرورش و رشد سلولهای انسانی و حیوانی در محیط آزمایشگاه است. همانطور که میدانید محصولی همچون مینی سانتریفیوژ ورتکس D-10000 یکی از دستگاههای چند منظوره آزمایشگاهی است که امکان میکس و جداسازی را به صورت همزمان فراهم میکند.
کشت سلول به ما این امکان را میدهد که بتوانیم ویروسها را در سلول تکثیر کنیم، در محیط آزمایشگاهی به تولید بافت انسانی بپردازیم، در مورد سلولهای سرطانی تحقیق کنیم و غیره.
در حقیقت کشت سلول با فراهم آوردن یک سیستم مدل کنترلشده و قابل تکرار، نقش بیبدیلی در پیشرفت دانش زیستشناسی و توسعه راهکارهای نوین درمانی ایفا میکند.
فرایند کشت سلول باید در محیطی استریل انجام شود. مراحل اصل این فرایند عبارتند از:

سابکالچرینگ (Subculturing) یا پاساژ دادن: هنگامی که سلولها به تراکم مناسبی رسیدند (confluency)، باید آنها را تقسیم و به ظروف جدید منتقل کرد. این کار برای جلوگیری از رشد بیش از حد و حفظ سلامت سلولها ضروری است. معمولاً برای جدا کردن سلولهای چسبنده (adherent cells) از سطح ظرف، از تریپسین استفاده میشود.
در این مرحله سلولها زیر میکروسکوپ بررسی میشوند و میتوان از آنها برای انجام تستهای اختصاصی نیز استفاده کرد.

سلولهایی که مستقیماً از بافتهای زنده (حیوان یا انسان) جدا شده و کشت میشوند. این سلولها ویژگیهای نزدیکتری به سلولهای بدن دارند اما عمر محدودی در کشت دارند.
سلولهایی که توانایی نامحدودی برای تقسیم و رشد در محیط کشت دارند (جاودانه شدهاند). این خطوط سلولی معمولاً از سلولهای سرطانی یا سلولهایی که به صورت ژنتیکی تغییر یافتهاند، مشتق میشوند.
برخی سلولها (مانند سلولهای خونی، برخی خطوط سلولی سرطانی) میتوانند به صورت معلق در محیط کشت رشد کنند. این سلولها در فلاسکهای بدون پوشش یا بیوراکتورها کشت میشوند و نیازی به سطح برای اتصال ندارند.
اکثر سلولها (مانند فیبروبلاستها، سلولهای اپیتلیال) برای رشد نیاز به اتصال به یک سطح دارند. این سلولها در فلاسکها، پلیتها یا دیشهای کشت سلول که از پلاستیک مخصوص (tissue culture-treated) ساخته شدهاند، رشد میکنند.
کشت سلول، نیازمند محیطی کاملاً کنترلشده و استریل است. دستیابی به نتایج دقیق و قابل اعتماد در آزمایشگاه کشت سلول، تا حد زیادی به کیفیت و نوع ظروف و وسایل مورد استفاده، بستگی دارد. در ادامه به معرفی مهمترین ظروف و تجهیزات لازم برای راهاندازی و نگهداری یک آزمایشگاه کشت سلول میپردازیم.
محیطهای کشت سلولی هم به صورت آماده و استریل در بازار موجود است و هم میتوان آنها را ساخت. که در این صورت باید پس از اتمام ساخت محیط کشت، با دقت بالایی آن را استریل کنید. برای رشد سلولها لازم است مواد مغذی نیز به محیط کشت افزوده شود. همچنین برای جلوگیری از بروز آلودگیهای میکروبی از مواد آنتی بیوتیکی نیز استفاده میشود.
این ظروف، محیط مناسبی را برای رشد و تکثیر سلولها فراهم میکنند و معمولاً از پلاستیکهای خاص شفاف و غیرسمی ساخته شدهاند که برای کشت سلول "تیمار" (treated) شدهاند تا امکان چسبندگی سلولهای چسبنده را فراهم آورند.
رایجترین ظروف برای کشت سلولهای چسبنده، فلاسکها هستند.
فلاسکها دارای سطوح مختلفی هستند (مثلاً T-25، T-75، T-175)، که نشاندهنده سطح رشد به سانتیمتر مربع است.
فلاسکهای کشت سلول دربهای مختلفی دارند (فیلتردار برای تبادل گاز یا بدون فیلتر برای سیستمهای بسته).
پلیتها از نظر تعداد چاهک متفاوتند. مثلاً ۶، ۱۲، ۲۴، ۴۸، ۹۶، ۳۸۴ چاهک که امکان انجام چند آزمایش را به طور همزمان فراهم میکنند.
از پلیت کشت سلول برای غربالگری داروها، سنجشهای سلولی و آزمایشهای با توان عملیاتی بالا استفاده میشود.
تجهیزات آزمایشگاه کشت سلول باید دما، رطوبت و غلظت CO2 مناسب برای رشد و زنده ماندن سلولها را فراهم کنند. این تجهسزات عبارتند از:
دستگاهی برای حفظ دمای ثابت (معمولاً ۳۷ درجه سانتیگراد)، رطوبت و غلظت CO2 (معمولاً ۵٪) که برای رشد سلولهای پستانداران ضروری است.
اتوکلاو برای استریل کردن ظروف شیشهای و سایر ابزارهای مقاوم به حرارت، با استفاده از بخار تحت فشار با دمای بالا استفاده میشود.
فریزر و تانک ازت برای نگهداری طولانیمدت سلولها در دمای بسیار پایین و حفظ زنده ماندن آنها استفاده میشود.
حمام آب برای گرم کردن محیط کشت و سایر محلولها و رساندنشان به دمای مناسب (معمولاً ۳۷ درجه سانتیگراد) استفاده میشود.
مهمترین مادهای که برای ضدعفونی و استریل کردن لوازم آزمایشگاه کشت سلول استفاده میشود، الکل ۷۰ درصد است.
کار با سلولهای انسانی و حیوانی و نگهداریشان در محیط آزمایشگاه بسیار و دقیق و حساس است. به همین خاطر پروتکلها و نکات مربوطه باید به دقت رعایت شوند. در ادامه به شرح برخی از این نکات میپردازیم:
شرایط عمومی ایدهآل برای زندگی سلولهای حیوانی و انسانی عبارت است از: داشتن محیط کشت مناسب و مغذی و بدون میکروب با PH حدودا ۷.۴، دمای ۳۷ درجه و CO2 حدودا ۵ درصد. علاوه بر این بعضی سلولها برای رشد شرایط اختصاصی دارند که حتما باید قبل از شروع کار در مورد آن تحقیق کنید.
برای جلوگیری از بروز آلودگی در کشت سلول باید شرایط استریل مورد نیاز به دقت رعایت شود. همچنین باید از ورود غیرضروری به آزمایشگاه کشت سلول نیز جلوگیری به عمل آید.
سلولها به طور مرتب با میکروسکوپ بررسی میشوند. با این کار زمان مناسب برای تغییر محیط کشت سلولها نیز تعیین میشود.
همانطور که گفته شد نگهداری سلولهای حیوانی و انسانی در محیط آزمایشگاه و به دور از آلودگی کاری دشوار و حساس است. برخی از مشکلات رایج این کار عبارتند از:
آلودگی میکروبی و قارچی موجب خراب شدن و از بین رفتن سلولها میشود. بنابراین رعایت شرایط استریل و استفاد از آنتی بیوتیک در محیط کشت بسیار ضروری است.
فراهم نبودن هریک از شرایط لازم برای رشد سلول مانند مواد مغذی، گاز CO2 و غیره موجب مردن و از بین رفتن سلولها میشود.

کشت سلول در طیف وسیعی از تحقیقات و کاربردهای صنعتی مورد استفاده قرار میگیرد:
کشت سلول امکان مطالعه مکانیسمهای بیماری در سطح سلولی و آزمایش اثربخشی و سمیت داروها را فراهم میکند.
ساخت بافتها برای پیوند و ترمیم بدن موجودات زنده، امکانی است که به وسیله کشت سلول فراهم شده است.
تولید بیوداروها و واکسنها در مقیاس بزرگ و همچنین بررسی اثر آنها برسلولهای انسانی و حیوانی از دیگر کاربردهای کشت سلول است.
کشت سلول نیز مانند هر حوزه دیگری در سالهای اخیر پیشرفتهای بسیاری کرده است. برخی از این پیشرفتها عبارتند از:
کشت سلول سه یعدی تکنیکی پیشرفته در زیست فناوری است. برخلاف کشت دوبعدی که سلولها در یک لایه و روی یک سطح رشد میکنند، در کشت سه بعدی سلولها در ماتریکسهایی مانند هیدروژلها یا داربستهای زیستی قرار میگیرند تا تعاملات سلول-سلول و سلول-ماتریکس شبیه شرایط فیزیولوژیکی بدن بازسازی شود.از این روش برای مطالعه رفتار سلولی، توسعه دارو، مدل سازی بمیاریها و مهندسی بافت مورد استفاده قرار میگیرد. کشت سه بعدی شباهت بیشتری به شرایط بدن دارد به همین خاطر نتاسج دقیقتری نیز ارائه میدهد.
بیوراکتورها ابزارهای پیشرفتهای در کشت سلولی هستند که محیطی کنترلشده برای رشد و تکثیر سلولها در مقیاس بزرگ فراهم میکنند. این دستگاهها با تنظیم پارامترهایی مانند دما، pH، اکسیژن و مواد مغذی، شرایط بهینهای برای کشت سلولهای سهبعدی یا معلق ایجاد میکنند و امکان تولید محصولات زیستی مانند پروتئینهای درمانی، واکسنها و سلولهای موردنیاز برای مهندسی بافت را فراهم میسازند. بیوراکتورها با قابلیت همزدن، جریاندهی و نظارت مداوم، بازده تولید را افزایش داده و از آلودگی جلوگیری میکنند، این موضوع آنها را به ابزاری کلیدی در زیستفناوری و تحقیقات پزشکی تبدیل کرده است.
فناوریهای نوین در کنترل و نظارت کشت سلولی، انقلابی در دقت و کارایی تحقیقات زیستفناوری ایجاد کردهاند. سیستمهای پیشرفته مانند حسگرهای زیستی (Biosensors) برای پایش لحظهای پارامترهایی نظیر pH، اکسیژن محلول و غلظت متابولیتها، و همچنین فناوریهای تصویربرداری پیشرفته مانند میکروسکوپهای فلورسانس و کانفوکال، امکان نظارت دقیق بر سلامت، رشد و رفتار سلولها را فراهم میکنند. هوش مصنوعی نیز برای تحلیل دادههای پیچیده کشت و پیشبینی الگوهای رشد سلولی به کار گرفته میشود. علاوه بر این، بیوراکتورهای هوشمند مجهز به اتوماسیون و سیستمهای کنترل دیجیتال، شرایط محیطی را بهصورت خودکار تنظیم میکنند و خطای انسانی را کاهش میدهند. این فناوریها نه تنها بازده تولید را افزایش میدهند، بلکه با بهبود نظارت بر آلودگی و کیفیت سلولها، کاربردهای پزشکی و صنعتی را نیز تقویت میکنند.
در این مقاله تلاش کردیم تا نکات ضروری درباره آزمایشگاه کشت سلول، تجهیزات و وسایل موردنیاز و روشهای گوناگون آن را شرح دهیم. پرورش و نگهداری سلولها در آزمایشگاه کشت سلول نیازمند رعایت دقیق شرایط محیطی، تکنیکهای آسپتیک و نظارت مستمر بر سلامت و رشد سلولهاست. با بهینهسازی محیط کشت، جلوگیری از آلودگی و استفاده از روشهای نظارت مانند میکروسکوپی میتوانید نتایج تحقیقاتی قابلاعتمادی به دست آورید. شرکت دناژن با ارائه این تجهیزات با کیفیت بالا و قیمت رقابتی شما را در این عرصه یاری میدهد. برای کسب اطلاعات بیشتر با مشاوران ما درتماس باشید.